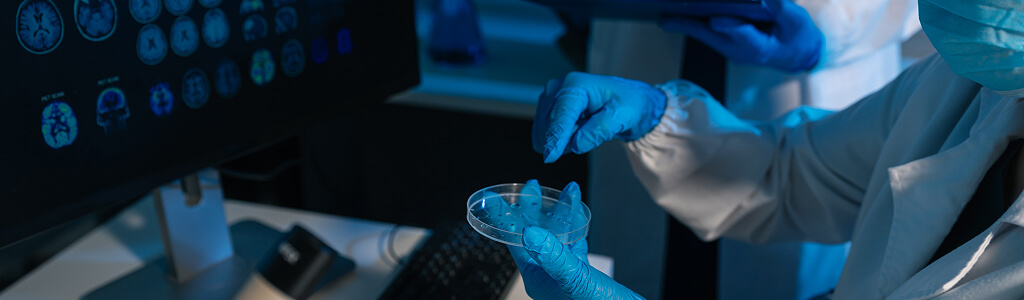
Addressing Data Governance Challenges In Pharma Pharmaceuticals

This background informs the technical and contextual discussion only and does not constitute clinical, legal, therapeutic, or compliance advice.
Problem Overview
In the realm of pharma pharmaceuticals, the complexity of data workflows presents significant challenges. The industry is characterized by stringent regulatory requirements, necessitating robust data management practices to ensure compliance and traceability. Inefficient data workflows can lead to delays in drug development, increased costs, and potential regulatory penalties. As organizations strive to streamline operations, the need for effective integration, governance, and analytics becomes paramount. This article explores the intricacies of enterprise data workflows within the pharma pharmaceuticals sector, highlighting the importance of addressing these challenges.
Mention of any specific tool or vendor is for illustrative purposes only and does not constitute an endorsement, recommendation, or validation of efficacy, security, or compliance suitability. Readers must conduct their own due diligence.
Key Takeaways
- Data integration is critical for ensuring seamless communication between disparate systems in pharma pharmaceuticals.
- Effective governance frameworks enhance data quality and compliance, reducing the risk of regulatory issues.
- Analytics capabilities enable organizations to derive actionable insights from data, improving decision-making processes.
- Traceability and auditability are essential for maintaining compliance and ensuring data integrity throughout the drug development lifecycle.
- Implementing a structured approach to data workflows can lead to significant operational efficiencies and cost savings.
Enumerated Solution Options
Organizations in the pharma pharmaceuticals sector can consider several solution archetypes to enhance their data workflows:
- Data Integration Platforms: Facilitate the seamless flow of data across various systems.
- Governance Frameworks: Establish policies and procedures for data management and compliance.
- Analytics Solutions: Provide tools for data analysis and visualization to support decision-making.
- Workflow Automation Tools: Streamline processes and reduce manual intervention in data handling.
- Compliance Management Systems: Ensure adherence to regulatory requirements and standards.
Comparison Table
| Solution Type | Integration Capabilities | Governance Features | Analytics Support | Workflow Automation |
|---|---|---|---|---|
| Data Integration Platforms | High | Low | Medium | Low |
| Governance Frameworks | Medium | High | Low | Medium |
| Analytics Solutions | Medium | Medium | High | Medium |
| Workflow Automation Tools | Low | Medium | Medium | High |
| Compliance Management Systems | Medium | High | Low | Medium |
Integration Layer
The integration layer is fundamental in establishing a cohesive data architecture within pharma pharmaceuticals. This layer focuses on data ingestion processes, ensuring that various data sources, such as laboratory instruments and clinical trial databases, can communicate effectively. Utilizing identifiers like plate_id and run_id facilitates the tracking of samples and experiments, enhancing traceability. A well-designed integration architecture minimizes data silos and promotes a unified view of information across the organization.
Governance Layer
The governance layer plays a crucial role in maintaining data quality and compliance in pharma pharmaceuticals. This layer encompasses the establishment of a governance framework that includes policies for data management, security, and compliance. Key elements such as QC_flag and lineage_id are essential for ensuring data integrity and traceability. By implementing a robust governance model, organizations can mitigate risks associated with data inaccuracies and enhance their ability to meet regulatory requirements.
Workflow & Analytics Layer
The workflow and analytics layer is pivotal for enabling data-driven decision-making in pharma pharmaceuticals. This layer focuses on the orchestration of workflows and the application of analytics to derive insights from data. Utilizing fields like model_version and compound_id allows organizations to track the evolution of analytical models and their corresponding compounds. By leveraging advanced analytics capabilities, organizations can optimize their workflows, leading to improved efficiency and faster time-to-market for new drugs.
Security and Compliance Considerations
In the highly regulated environment of pharma pharmaceuticals, security and compliance are paramount. Organizations must implement stringent security measures to protect sensitive data from unauthorized access and breaches. Compliance with regulations such as FDA guidelines and GDPR is essential to avoid legal repercussions. A comprehensive approach to security and compliance includes regular audits, employee training, and the adoption of best practices in data management.
Decision Framework
When evaluating solutions for enterprise data workflows in pharma pharmaceuticals, organizations should consider a decision framework that includes criteria such as integration capabilities, governance features, analytics support, and workflow automation. This framework can guide stakeholders in selecting the most suitable solutions that align with their operational needs and compliance requirements. A thorough assessment of existing workflows and data management practices is also essential to identify areas for improvement.
Tooling Example Section
Various tools are available to support enterprise data workflows in pharma pharmaceuticals. These tools can range from data integration platforms to analytics solutions, each serving a specific purpose within the workflow. For instance, organizations may utilize data integration tools to streamline data ingestion processes, while analytics platforms can provide insights into operational efficiency. It is crucial for organizations to evaluate their specific needs and select tools that complement their existing infrastructure.
What To Do Next
Organizations in the pharma pharmaceuticals sector should begin by assessing their current data workflows and identifying pain points. Engaging stakeholders across departments can provide valuable insights into existing challenges and opportunities for improvement. Additionally, exploring potential solution archetypes and developing a roadmap for implementation can facilitate a smoother transition to enhanced data workflows. For further exploration, organizations may consider resources such as Solix EAI Pharma as one example among many.
FAQ
Common questions regarding enterprise data workflows in pharma pharmaceuticals include inquiries about best practices for data integration, the importance of governance frameworks, and how analytics can drive decision-making. Organizations often seek guidance on compliance requirements and the role of technology in enhancing data workflows. Addressing these questions can help organizations navigate the complexities of data management in the pharma pharmaceuticals sector.
Operational Scope and Context
This section provides additional descriptive context for how the topic represented by the primary keyword is commonly framed within regulated enterprise data environments. The intent is informational only and reflects observed terminology and structural patterns rather than evaluation, instruction, or guidance.
Concept Glossary (## Technical Glossary & System Definitions)
- Data_Lineage: representation of data origin, transformation, and downstream usage.
- Traceability: ability to associate outputs with upstream inputs and processing context.
- Governance: shared policies and controls surrounding data handling and accountability.
- Workflow_Orchestration: coordination of data movement across systems and roles.
Operational Landscape Patterns
The following patterns are frequently referenced in discussions of regulated and enterprise data workflows. They are illustrative and non-exhaustive.
- Ingestion of structured and semi-structured data from operational systems
- Transformation processes with lineage capture for audit and reproducibility
- Analytics and reporting layers used for interpretation rather than prediction
- Access control and governance overlays supporting traceability
Capability Archetype Comparison
This table illustrates commonly described capability groupings without ranking, preference, or suitability assessment.
| Archetype | Integration | Governance | Analytics | Traceability |
|---|---|---|---|---|
| Integration Platforms | High | Low | Medium | Medium |
| Metadata Systems | Medium | High | Low | Medium |
| Analytics Tooling | Medium | Medium | High | Medium |
| Workflow Orchestration | Low | Medium | Medium | High |
Safety and Neutrality Notice
This appended content is informational only. It does not define requirements, standards, recommendations, or outcomes. Applicability must be evaluated independently within appropriate legal, regulatory, clinical, or operational frameworks.
Reference
DOI: Open peer-reviewed source
Title: Data governance in the pharmaceutical industry: A systematic review
Context Note: This reference is included for descriptive, conceptual context relevant to the topic area. Descriptive-only conceptual relevance to pharma pharmaceuticals within The keyword represents an informational intent focused on enterprise data integration within the pharma pharmaceuticals domain, emphasizing governance and analytics in regulated workflows.. It does not imply endorsement, validation, guidance, or applicability to any specific operational, regulatory, or compliance scenario.
Author:
Levi Montgomery is contributing to projects focused on the integration of analytics pipelines across research, development, and operational data domains in pharma pharmaceuticals. His experience includes supporting validation controls and auditability for analytics in regulated environments, emphasizing the importance of traceability in analytics workflows.
DOI: Open the peer-reviewed source
Study overview: Data governance in the pharmaceutical industry: A systematic review
Why this reference is relevant: Descriptive-only conceptual relevance to pharma pharmaceuticals within the context of enterprise data integration, governance, and analytics in regulated workflows.
DISCLAIMER: THE CONTENT, VIEWS, AND OPINIONS EXPRESSED IN THIS BLOG ARE SOLELY THOSE OF THE AUTHOR(S) AND DO NOT REFLECT THE OFFICIAL POLICY OR POSITION OF SOLIX TECHNOLOGIES, INC., ITS AFFILIATES, OR PARTNERS. THIS BLOG IS OPERATED INDEPENDENTLY AND IS NOT REVIEWED OR ENDORSED BY SOLIX TECHNOLOGIES, INC. IN AN OFFICIAL CAPACITY. ALL THIRD-PARTY TRADEMARKS, LOGOS, AND COPYRIGHTED MATERIALS REFERENCED HEREIN ARE THE PROPERTY OF THEIR RESPECTIVE OWNERS. ANY USE IS STRICTLY FOR IDENTIFICATION, COMMENTARY, OR EDUCATIONAL PURPOSES UNDER THE DOCTRINE OF FAIR USE (U.S. COPYRIGHT ACT § 107 AND INTERNATIONAL EQUIVALENTS). NO SPONSORSHIP, ENDORSEMENT, OR AFFILIATION WITH SOLIX TECHNOLOGIES, INC. IS IMPLIED. CONTENT IS PROVIDED "AS-IS" WITHOUT WARRANTIES OF ACCURACY, COMPLETENESS, OR FITNESS FOR ANY PURPOSE. SOLIX TECHNOLOGIES, INC. DISCLAIMS ALL LIABILITY FOR ACTIONS TAKEN BASED ON THIS MATERIAL. READERS ASSUME FULL RESPONSIBILITY FOR THEIR USE OF THIS INFORMATION. SOLIX RESPECTS INTELLECTUAL PROPERTY RIGHTS. TO SUBMIT A DMCA TAKEDOWN REQUEST, EMAIL INFO@SOLIX.COM WITH: (1) IDENTIFICATION OF THE WORK, (2) THE INFRINGING MATERIAL’S URL, (3) YOUR CONTACT DETAILS, AND (4) A STATEMENT OF GOOD FAITH. VALID CLAIMS WILL RECEIVE PROMPT ATTENTION. BY ACCESSING THIS BLOG, YOU AGREE TO THIS DISCLAIMER AND OUR TERMS OF USE. THIS AGREEMENT IS GOVERNED BY THE LAWS OF CALIFORNIA.
-
 White Paper
White PaperEnterprise Information Architecture for Gen AI and Machine Learning
Download White Paper -

-

-

